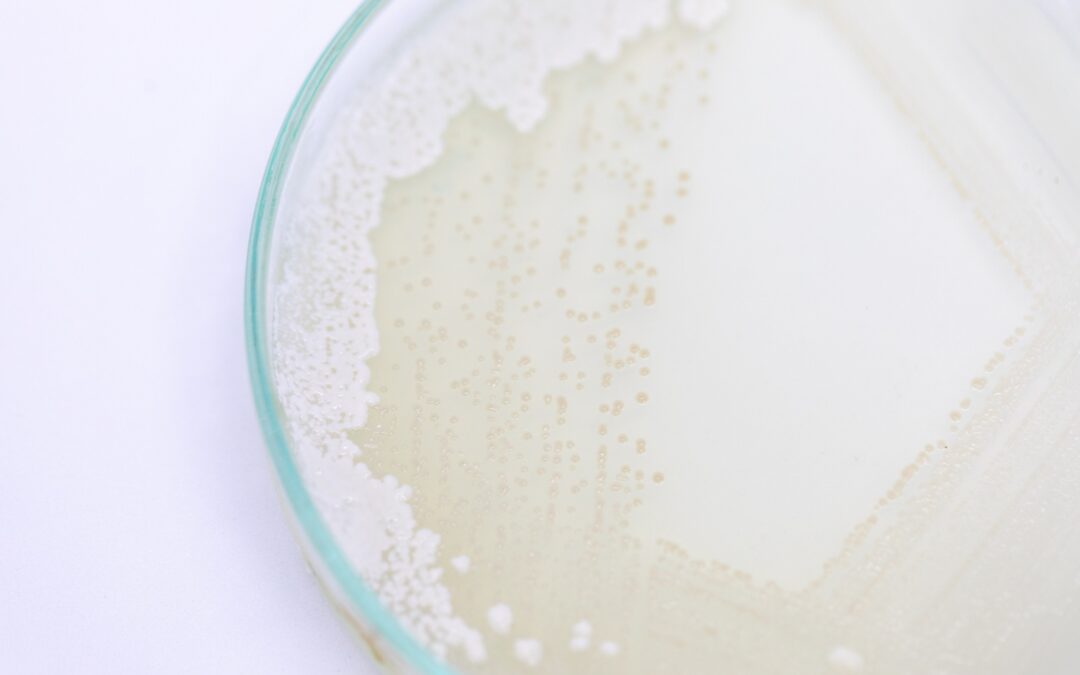
Na czym polega bioprotekcja mleka?

utworzone przez admin | maj 4, 2020 | Bez kategorii
Na czym polega bioprotekcja mleka? Nawet osobom, które niezwiązane są z branżą mleczarską, zdarzało się usłyszeć zwrot „bioprotekcja mleka”. Nic w tym dziwnego. Szczepionki mleczarskie mają ogromny wpływ na wyroby mleczne, które spożywamy....

utworzone przez admin | maj 4, 2020 | Bez kategorii
Chociaż od kilku lat trwają dyskusje o tym, czy mleko krowie ma rzeczywiście wartość dietetyczną dla człowieka, wciąż przedstawiane są dowody na to, że dostarcza ono nam wielu składników odżywczych. Wbrew pozorom mleka krowiego...

utworzone przez admin | maj 4, 2020 | Bez kategorii
Na mastitis, czyli schorzenie gruczołu mlekowego co roku choruje około 20-50% krów w Polsce. Wiele mówi się o tym, że w walce ze schorzeniem najskuteczniejszy jest antybiotyk. Jednak jeśli dostanie się on do mleka,...

utworzone przez admin | maj 4, 2020 | Bez kategorii
Probiotyki to wyselekcjonowane kultury bakterii kwasu mlekowego. Przyczyniają się do utrzymania prawidłowej flory bakteryjnej, korzystnie wpływając na funkcjonowanie przewodu pokarmowego. Bakterie fermentacji mlekowej Lactobacillus mają...

utworzone przez admin | maj 4, 2020 | Bez kategorii
Badanie sera. Analiza sensoryczna i fizykochemiczna Badania sensoryczne przeprowadzane są przez wyspecjalizowanych degustatorów w zakresie konsystencji, barwy, smaku i zapachu. W przypadku analizy fizykochemicznej badaniu zostaje poddany...

utworzone przez admin | maj 2, 2020 | Bez kategorii
Jogurty, sery, twarogi – kto z nas nie sięga po nabiał? Te najwyższej klasy produkty, które tak cenimy, są efektem naturalnych mechanizmów, przebiegających pod okiem fachowców. Do ich uzyskania niezbędne...